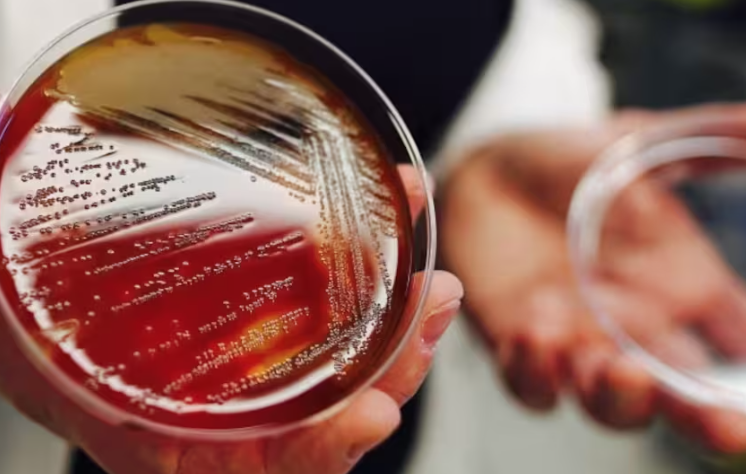
640-20260408-123951-69d6af0719c0f

在新冠逐渐淡出公众视线的同时,加拿大另一种更“低感染但高致命”的病毒正在悄悄上升。

根据最新统计,2025年加拿大侵袭性脑膜炎球菌疾病(IMD)病例已超过150例,创下十多年来最高水平。这种疾病虽然相对少见,但一旦发生,发展极快,后果严重。
公共卫生专家提醒,即使发病率不高,这类感染的风险依然不容忽视,尤其是对儿童和年轻人来说。

侵袭性脑膜炎球菌疾病是由一种常见细菌引起的严重感染。这种细菌本身并不罕见,大约每10个人中就有1人可能携带,但大多数情况下不会致病。
真正危险的是,当细菌进入血液或侵入中枢神经系统时,会迅速引发严重后果,包括脑膜炎、败血症、器官衰竭,甚至死亡。

数据显示,这种疾病在加拿大的死亡率约为14%。此外,还有15%到20%的患者可能留下长期后遗症,例如听力损失、神经损伤,甚至截肢。
更值得关注的是,婴幼儿和年轻人是风险最高的人群。
在2000年代初疫苗推广后,加拿大相关病例曾大幅下降。
2021年,由于疫情期间的防疫措施,这一疾病的病例数降至历史低点,全国仅48例。

但随着社会恢复正常,病例开始逐步回升:
-
2022年约74例
-
2023年接近100例
-
2024年达到132例
-
2025年进一步上升至155例
-
而仅2026年前几个月,全国已报告超过60例!!!

专家表示,这种回升在一定程度上是“预料之中”,因为许多传染病在疫情后都出现反弹。
但脑膜炎球菌感染的特殊之处在于,它的不确定性更强,也更难预测。
目前来看,加拿大各省情况差异较大。
曼省近几年病例明显增加,并出现由W型菌株引发的局部暴发,2025年23例中已有4人死亡。
安省方面,2024年共有30例,其中6例死亡;2025年上升至39例,今年截至目前已有40多例……
魁省2024年和2025年病例也维持在较高水平,并出现多例死亡。
专家指出,不同地区流行的菌株不同,这也是为什么有些省份上升明显,而有些地区相对稳定。
这种疾病最令人担忧的,是它的发展速度。

一名来自曼省的11岁女孩,最初只是被诊断为普通耳部感染。但短短几个小时内,她开始高烧、剧烈头痛,并持续呕吐。
家人意识到情况异常后紧急送医,最终被确诊为细菌性脑膜炎,并伴随脑部血栓。
她接受了多项紧急治疗,在医院住了10天后才逐渐恢复。
类似案例提醒公众,这种感染往往来势凶猛,不能用“普通感冒”去判断。
另一个值得关注的趋势,是疫苗接种率的下降。

数据显示,加拿大幼儿脑膜炎球菌C型疫苗的接种率,从2019年的90%以上下降到2024年的不足84%。
青少年接种覆盖率同样出现下滑。
专家认为,这与疫情期间医疗服务中断、疫苗犹豫以及家庭医生资源不足等多种因素有关。
虽然目前没有一种疫苗可以覆盖所有菌株,但接种仍然是预防严重感染最有效的方式。
侵袭性脑膜炎球菌感染的早期症状,与普通感染非常相似,这也是它危险的原因之一。

常见初期表现包括发烧、头痛、疲劳、恶心等。

但如果出现以下情况,需要特别警惕:
-
持续加重的剧烈头痛
-
颈部僵硬
-
畏光
-
意识混乱或异常嗜睡
-
皮肤出现异常皮疹
这些都可能是感染已经发展到严重阶段的信号!!!
多位专家强调,家长的直觉非常重要。
当孩子的状态明显“和平时不一样”,或者症状进展异常迅速时,应尽快就医,而不是等待症状自行缓解。

因为这种疾病可能在数小时内迅速恶化,延误治疗的后果非常严重。
侵袭性脑膜炎球菌疾病并不是一个新问题,但它的回升提醒我们,某些传染病从未真正消失。
在整体风险仍然可控的情况下,大家更需要提高认知,而不是恐慌。了解症状、关注疫苗接种、在关键时刻及时就医,依然是最现实、也最有效的应对方式!
Ref:
https://www.cbc.ca/news/health/invasive-meningococcal-disease-rising-9.7151929












































